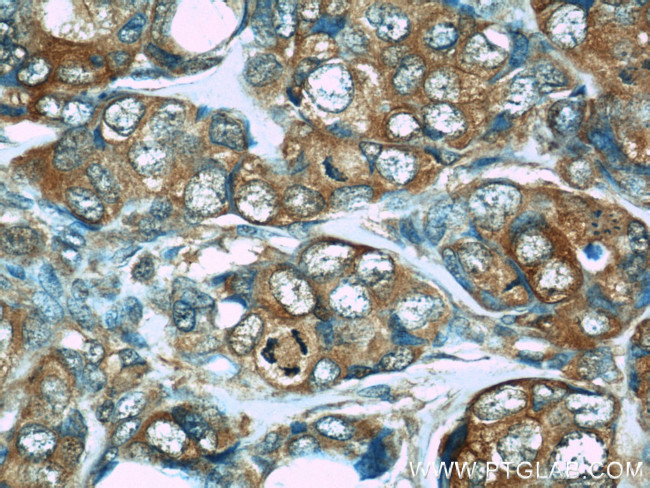
PDCD4 Antibody in Immunohistochemistry (Paraffin) (IHC (P))

Search
Proteintech
PDCD4 Monoclonal Antibody (1F1A11)
{{$productOrderCtrl.translations['antibody.pdp.commerceCard.promotion.promotions']}}
{{$productOrderCtrl.translations['antibody.pdp.commerceCard.promotion.viewpromo']}}
{{$productOrderCtrl.translations['antibody.pdp.commerceCard.promotion.promocode']}}: {{promo.promoCode}} {{promo.promoTitle}} {{promo.promoDescription}}. {{$productOrderCtrl.translations['antibody.pdp.commerceCard.promotion.learnmore']}}
产品信息
66100-1-IG
种属反应
已发表种属
宿主/亚型
分类
类型
克隆号
抗原
偶联物
形式
浓度
规格
纯化类型
保存液
内含物
保存条件
运输条件
产品详细信息
Immunogen sequence: TPIIQEYFE HGDTNEVAEM LRDLNLGEMK SGVPVLAVSL ALEGKASHRE MTSKLLSDLC GTVMSTTDVE KSFDKLLKDL PELALDTPRA PQLVGQFIAR AVGDGILCNT YIDSYKGTVD CVQARAALDK ATVLLSMSKG GKRKDSVWGS GGGQQSVNHL VKEIDMLLKE YLLSGDISEA EHCLKELEVP HFHHELVYEA IIMVLESTGE STFKMILDLL KSLWKSSTIT VDQMKRGYER IYNEIPDINL DVPHSYSVLE RFVEECFQAG IISKQLRDLC PSRGRKRFVS EGDGGRLKPE SY (169-469 aa encoded by BC026104)
靶标信息
Apoptosis, also known as programmed cell death, plays major roles in development and normal tissue turnover in addition to tumor formation. During this process, the expression patterns of numerous genes are radically altered. One such gene is the programmed cell death protein 4 (PDCD4), whose expression was found to be upregulated in all cell lines following the onset of apoptosis. PDCD4 encodes a tumor suppressor protein whose expression is lost in carcinomas of breast, colon, lung and prostate. It can bind to and inhibit the helicase activity of the eukaryotic translation initiation factor 4A and inhibit the transactivation and transformation mediated by the transcription factor AP-1. The kinase Akt regulates PDCD4 by phosphorylation, decreasing the ability of PDCD4 to interfere with the transactivation of AP-1-responsive promoter by c-Jun. There are two known isoforms of PDCD4.
仅用于科研。不用于诊断过程。未经明确授权不得转售。
生物信息学
蛋白别名: MGC33046; MGC33047; Neoplastic transformation inhibitor protein; nuclear antigen H731; Nuclear antigen H731-like; programmed cell death 4 (neoplastic transformation inhibitor); Programmed cell death protein 4; Protein 197/15a; RP11-348N5.4; unnamed protein product
基因别名: H731; PDCD4
UniProt ID: (Human) Q53EL6
Entrez Gene ID: (Human) 27250